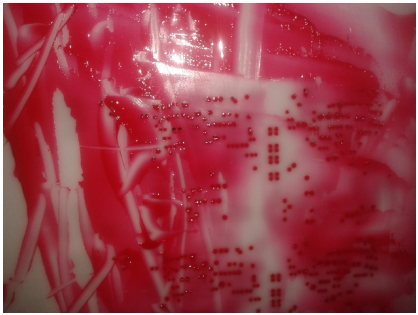

| Sign In | Join Free | My enlightcorp.com |
|
Brand Name : YUSHUNLI
Model Number : SME-750
Certification : CE
Place of Origin : China Dongguan
MOQ : 1set
Price : USD1000~10000
Payment Terms : L/C, D/A, D/P, T/T, Western Union, MoneyGram
Supply Ability : 200Sets/Month
Delivery Time : 5-7work days
Packaging Details : plywooden case
Stencil size : 750mm(L) ×750mm(W) × 40mm(H)as max
Liquid tank capacity : 40L(as max)
Wash method : 360°double side rotary nozzles liquid spray wash
Dry methods : 360°double side rotary nozzles spray liquid air blow dry
Clean time : 3-5 min(solder paste stencil)
Dry time : 3-5 min(solder paste stencil)
Air supply : 0.5Mpa~ 0.7Mpa
Air consumption : 400-600L/min
0.5Mpa~ 0.7Mpa Pneumatic Stencil Cleaning Machine For Solder Paste Stencil Glue Cooper/Rubber Stencil
Pneumatic Stencil Cleaner
Model:SME-750
SME-750 Main Features:
1. SUS 304 structure, Acid and Alkali corrosion resistance, 10 years lifespan.
2. All liquid pipes are SUS304, no plastic pipes at all.
3. Driven by compressed air, no use electric power,100% safe by using solvent.
4. One button easy operation, clean and dry complete automatically.
5. 360°rotate spray rods on both sides , ensure good cleaning quality and stable stencil tension.
6. Liquid recycle use, low consumption.
7. Inner-lock safety door and safety valve, once open, machine will be stopped immediately.
8. 3-level precise liquid filtering system. Liquid used repeatedly.
9. Super well-known Pneumatic parts from all over the word manufactures.
10. Modular design, easy maintenance.
SME-750 Flow chart:

SME-750 main spec:
| S/N | ITEM | SPEC | REMARKS |
| 1 | Stencil size | 750mm(L) ×750mm(W) × 40mm(H)as max | |
| 2 | Liquid tank capacity | 40L(as max) | |
| 3 | Wash method | 360°double side rotary nozzles liquid spray wash | |
| 4 | Dry methods | 360°double side rotary nozzles spray liquid air blow dry | |
| 5 | Clean time | 3-5 min(solder paste stencil) | |
| 6 | Dry time | 3-5 min(solder paste stencil) | |
| 7 | Filter systems | 1mm SUS 304 fliter net—Protect pum; 20um filter bag — for lables, screws; 1um filter elements— for solder balls,red glue. | Liuqid recirculation use |
| 8 | Air supply | 0.5Mpa~ 0.7Mpa | |
| 9 | Air consumption | 400-600L/min | |
| 10 | Net weight | 230Kg | |
| 11 | Vent size | Φ120xH30mm | |
| 12 | Machine size | 800mm(L)×950mm(W)×1650mm(H) |
Cleaning result comparision
Before cleaning

After cleaning

solder paste stencil red glue rubber stencil

red glue cooper stencil
Standard equipped with solvent add in and discharge function. Solvent add in and discharge very convienent.

Super wel-known pneumatic parts guarantee a stable, reliable and high quality machine and good clean result.

|
|
Pneumatic Stencil Cleaning Machine Images |